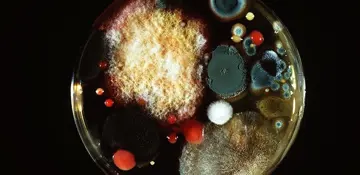

شماره ۱۰۱۶
آزمایشگاه - صفحه 9
شماره ۱۰۱۶
شماره ۱۰۱۴
شماره ۱۰۱۲
شماره ۱۰۱۱
شماره ۱۰۱۱
یک مرد 62 ساله دچار نارسایی مزمن کلیه میگفت ازهفتهی گذشته تحمل انجام ورزش را ندارد.
شماره ۱۰۱۱
شماره ۱۰۱۰
آنفلوانزا بیماری ویروسی است که به دستگاه فوقانی تنفس حمله میکند و ممکناست عفونت جدی ایجاد کند.
شماره ۱۰۰۶
شماره ۱۰۰۳
شماره ۹۹۶
درخبرها آمده بود که رویکرد تازهیی برای غربالگری پاتوژنها پیشنهاد شده که بسیار سریعتر از روشهای رایج تجاری جواب میدهد.
شماره ۹۹۳